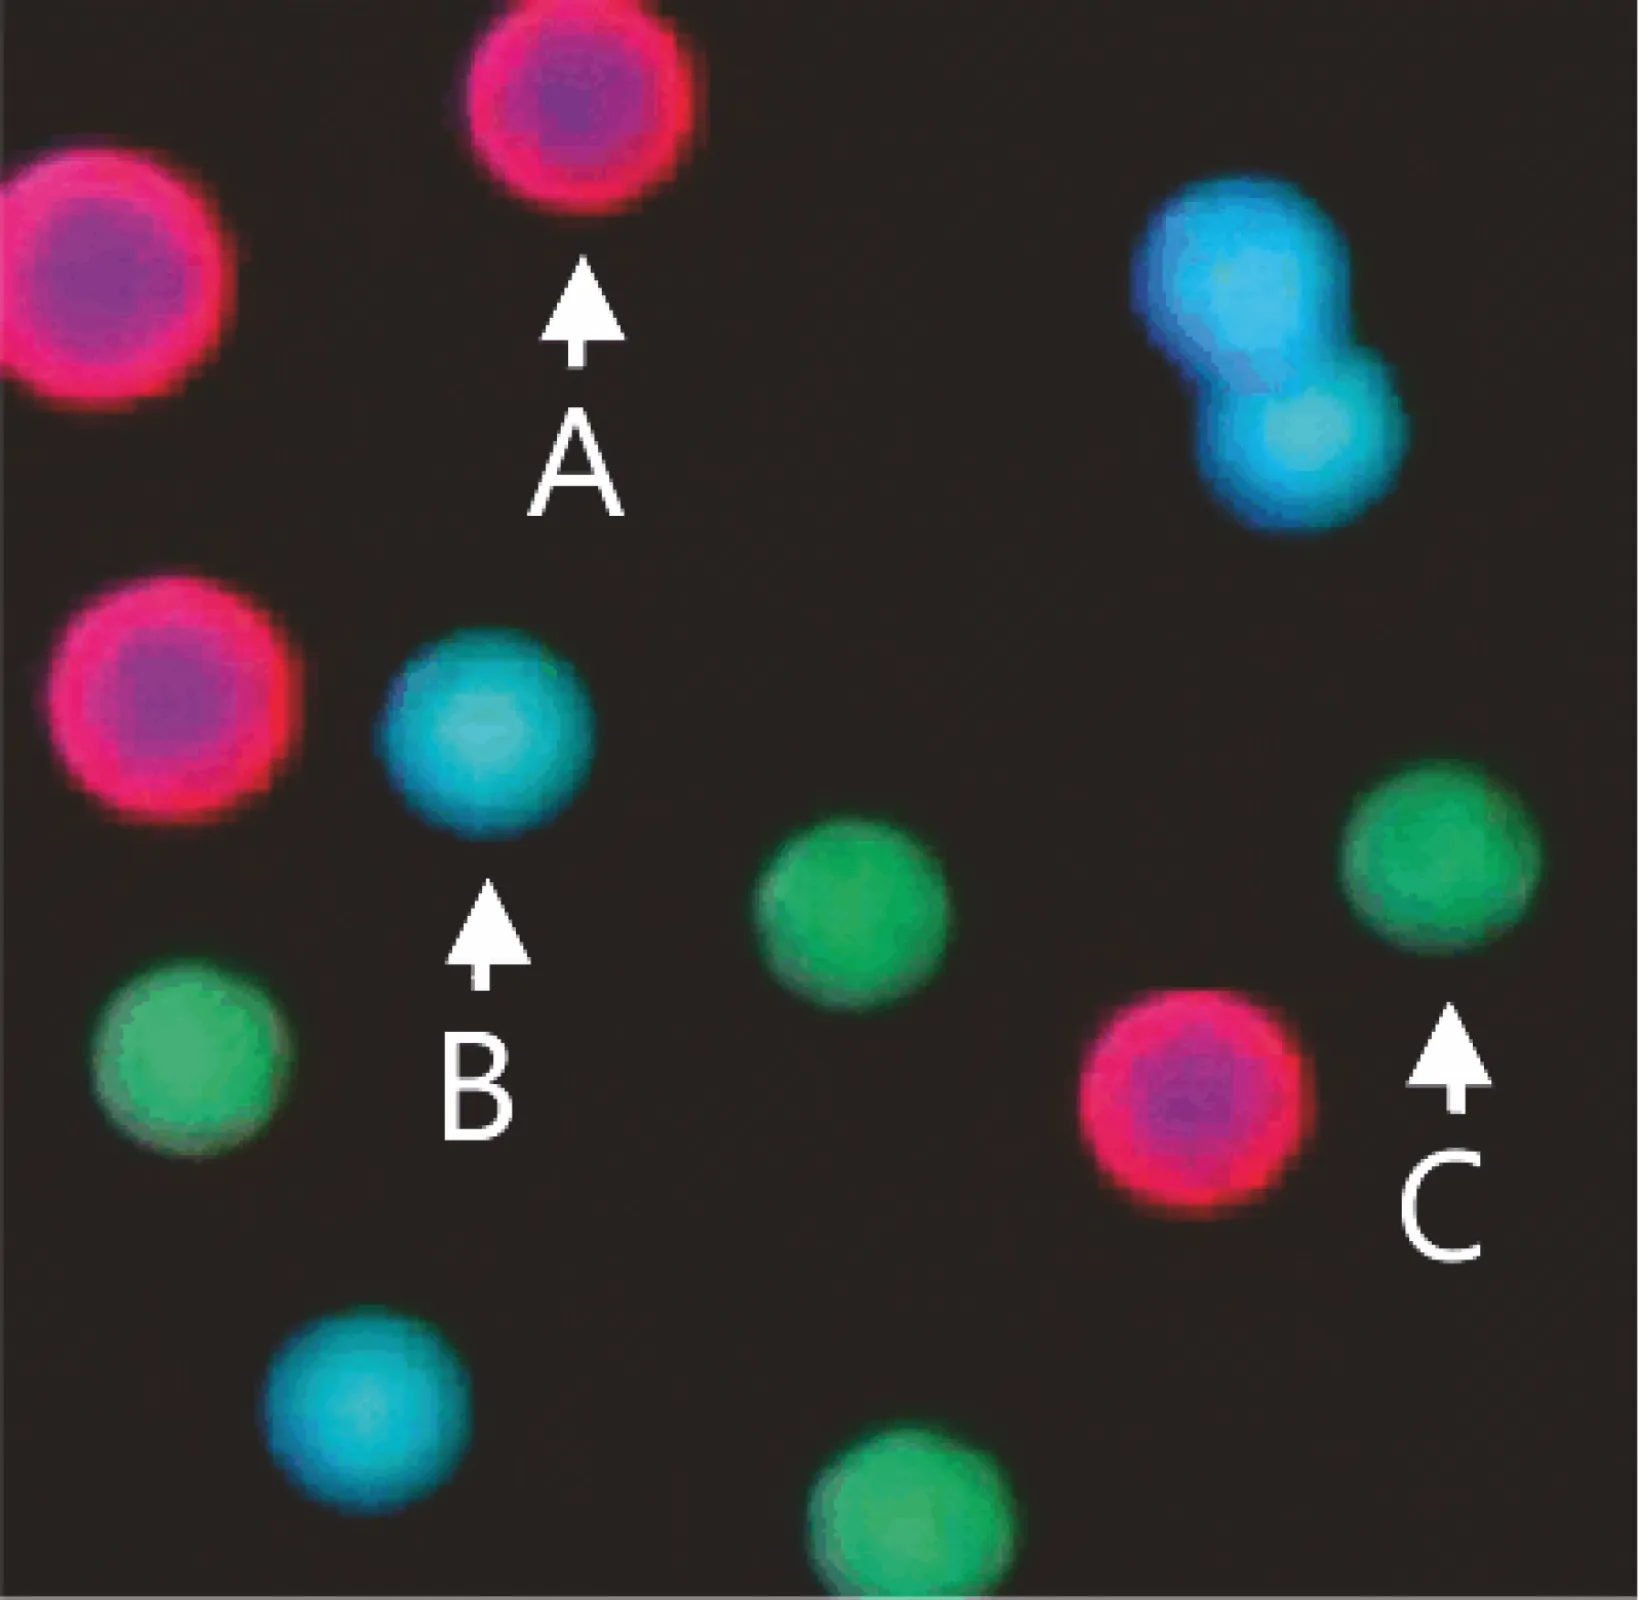
evaluation of the beads

Beadassay
Exhibitor
Attomol GmbH Molekulare Diagnostika
The antibody Beadassay was developed as a semiquantitative multi-parameter testing system for the simultaneous detection or differentiation of antibodies in patients sera. In comparison to line blots it is more precise, has a wider dynamic measuring range and can be automatically processed. The multiparameter function of the microplate-based antibody Beadassay makes it possible to detect several analytes in one reaction vessel as well as to integrate various controls to increase test reliability and its precision.
The antibody Beadassay is a fluorescence-based assay. Specific antigens are bound at up to 18 size- and fluorescence-coded beads. The beads carrying antigens are permanently immobilized at the bottom of a well on a common 96-well microplate (12 modules, 8 wells each) adhering to the solid phase inbetween various steps of incubation. In case of positive samples the antibodies from the patient‘s serum bind to the relevant beads during the incubation. After the incubation with a secondary fluorescence-coded human specific antibody the fluorescent beads are measured with Caleidoscan 100. In consideration of the detected sizes and fluorescence of the beads the exact allocation of the antigens and the positive or negative determination takes place by decoding the beads.
evaluation of the beads